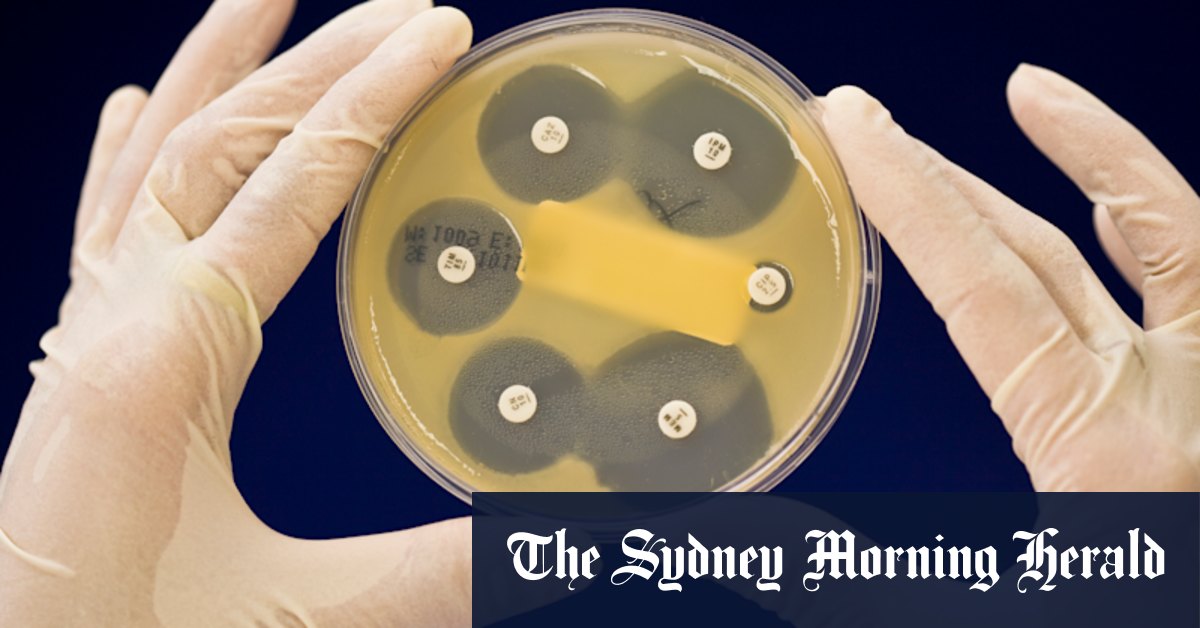

Her push comes as the Trump administration hollows out US research and medical institutions, including the Centre for Disease Control, the Food and Drug Administration, and the National Institutes of Health, which is the largest public funder of biomedical research in the world.
Loading
Australian medical research institutes have already been forced to suspend projects on malaria, tuberculosis and women’s health as the National Institutes of Health terminates billions of dollars for research organisations outside the United States.
“We could more than double the amount spent from the MRFF every year, while keeping more money in the fund than it was intended to hold,” Ryan told this masthead.
“It’s a win-win for Australians concerned about our healthcare system, for medical researchers, and for our economy. Hundreds of high-quality research proposals have missed out on funding in recent years. Increased investment in medical research won’t just secure our research sector and guarantee its growth and longevity – it will improve health outcomes for all Australians.”
Burnet Institute director Professor Brendan Crabb – who has likened the US cuts to “having a bomb thrown into the middle of science” – said medical researchers were in desperate need of further support.
“It is rare to have a ready-made answer. Yet, in the MRFF, we have what we need already in the bank,” he said.
“The funds simply need to flow as originally intended. This can happen, while also maintaining this vital fund for future generations.”
Australian Academy of Science president Professor Chennupati Jagadish said it was time to remove the “arbitrary funding cap” so the fund could deliver on its purpose of supporting research and innovation.
“While the fund continues to grow in value, there is no reason to cap disbursements and, in so doing, to cap cures,” he said.
Association of Australian Medical Research Institutes chief executive Dr Saraid Billiards said funding delivered breakthroughs.
Loading
“Spending this available money would help stabilise our research institutes, and at the same time enable the government to realise the ambitions of its Health and Medical Research Strategy,” she said.
Medicines Australia chief executive Liz de Somer agreed boosting investment would improve lives, boost economic productivity, and make the health system more sustainable.
“The government needs to further unlock this ongoing research fund to meet these objectives,” she said.
A Health Department spokesperson said the government was finalising a 10-year national strategy for health and medical research.
“A key area of focus … is to ensure that funding for health and medical research is sufficient and strategically co-ordinated across government, industry, not-for-profit and philanthropic sector,” they said.
Public and stakeholder consultation on the draft strategy is under way, and the final strategy will be delivered by the end of the year.
The spokesperson said the $6.5 billion commitment over 10 years was designed to give predictability and a guaranteed level of investment each year. It is on top of $1 billion provided each year through the National Health and Medical Research Council.
Cut through the noise of federal politics with news, views and expert analysis. Subscribers can sign up to our weekly Inside Politics newsletter here.